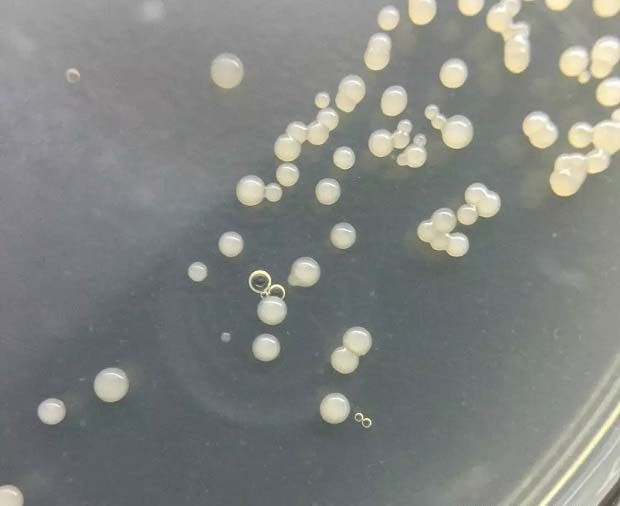
什么是真菌的繁殖体？

什么是真菌的繁殖体?
什么是真菌的繁殖体?
真菌的营养体生长到一定时期后开始形成繁殖体,产生各种类型的孢子。真菌的繁殖方式分无性繁殖和有性繁殖。
1、无性繁殖
真菌的无性繁殖指不经过细胞生成***的结合,直接由营养菌丝分化形成孢子的繁殖方式。通过无性繁殖组成的孢子称为无性孢子。常见的无性繁殖有游动孢子、孢囊孢子、分生孢子等。
2、有性繁殖
真菌的有性繁殖是指由两个交配的性细胞或***结合形成孢子的繁殖方式。通过有性繁殖形成的孢子称为有性孢子。
真菌的有性繁殖方式有多种,低等真菌两个单细胞的营养体或两根菌丝就可结合,多数真菌是在菌丝体上分化出***进行交配。真菌的***称为配子囊,配子囊内的性细胞称配子。两种不同性别的配子囊或配子,大小、形状相同者,称为同型配子囊或同型配子,大小、形状不同者,则称为异型配子囊或异型配子,经过有性繁殖,不同真菌可分别形成不同的有性孢子。
真菌的有性孢子一般是休眠孢子,一年往往只发生一代,产生数量也较少,但对环境的抵抗力较强,有度过不良环境的作用。
真菌从一种孢子萌发开始,经过生长和发育,最后产生同一种孢子的全过程称为生活史,亦称为个体发育史。真菌典型的生活史一般包括无性阶段和有性阶段,即营养菌丝在适宜的条件下产生无性孢子,无性孢子萌发形成芽管,并继续生长形成新的菌丝体,这是无性阶段,在一个生长季节常循环多次。
至生长后期进入有性阶段,菌丝体上开始形成两***配细胞,两性细胞经过质配、核配和减数分裂后,产生有性孢子,有性孢子萌发再产生菌丝体。
大部分真菌在其整个生活史中只产生一种无性孢子和一种有性孢子,也有少数真菌在其生活史中可产生多种类型的孢子,产生多种类型孢子的现象称为真菌的多型性,如锈菌典型的生活史可产生五种类型的孢子,即冬孢子、夏孢子、锈孢子、担孢子及性孢子。如果各种类型的孢子在同一寄主上就可完成其生活史的称为单主寄生;需要在两种不同的寄主上才能完成其生活史的称为转主寄生。
有些真菌不产生有性孢子,只以无性生殖完成其生活史,如许多半知菌。而有的真菌在其生活史中几乎没有无性繁殖,如黑粉菌和锈菌。
在细胞生物的五界系统中,真菌作为一界与动物界、原生界和原核界鼎足而立。真菌界下分黏菌门和真菌门,真菌门下分鞭毛菌、结合菌、子囊菌、担子菌和半知菌五个亚门。
